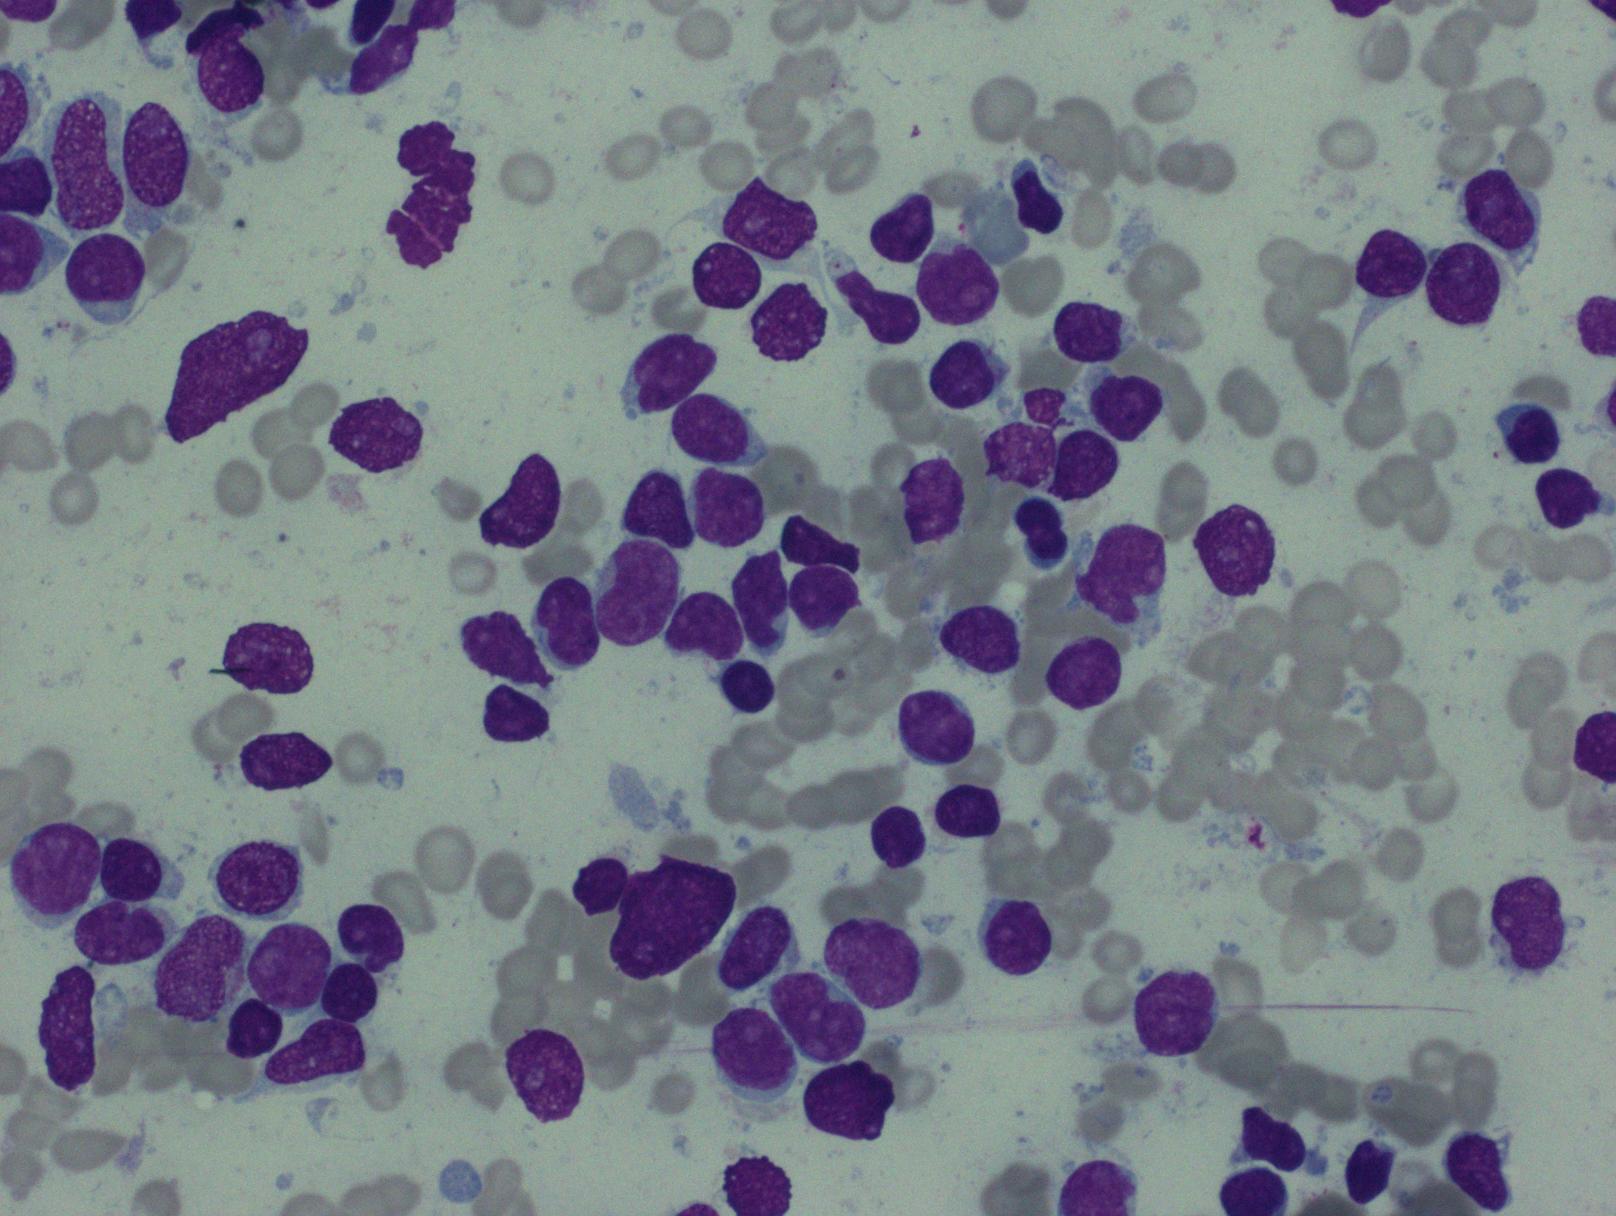

急性髓系白血病不伴成熟
Acute Myeloid Leukemia Without Maturation
概述:
急性髓系白血病不伴成熟具有高原始细胞(髓系母细胞)计数的特征(≥90%非有核红细胞),髓系表型(≥3%母细胞 MPO 阳性或有 Auer 小体),但分化成熟中的髓系细胞很少(<10%)。类似于 FAB 形态学分类的 M1。不符合 AML 伴重现性遗传学异常、AML 伴骨髓增生异常相关改变和治疗相关 AML 的诊断标准。
诊断要点:
- 占所有 AML 的 5-10%,成人多见(中位年龄 46 岁)。可表现为全血细胞减少或白细胞计数增高含大量循环母细胞。
- 细胞形态学:母细胞可以具有髓系特征如胞质含稀疏颗粒甚至偶见 Auer 小体,但有的病例母细胞类似淋巴母细胞。
- 母细胞计数 ≥90%的非有核红细胞,细胞化学染色 MPO、SBB 至少有 3%的母细胞阳性;分化成熟中的髓系细胞<10%。
- 骨髓活检通常密度极度增高(偶正常或减低),细胞不成熟,需要做免疫组织化学染色方可诊断。
- 免疫表型:幼稚细胞表达 MPO 和一种或多种髓系抗原 CD13. CD33. CD117,70%病例表达 CD34. HLA-DR;通常不表达 CD15. CD65. CD14. CD64;部分病例表达 CD11b;胞浆 CD3. CD79a、CD22 阴性;30%病例表达 CD7,10-20%可表达淋巴细胞抗原 CD2. CD4. CD19. CD56 中的一种或多种。
- 遗传学:无特异性遗传学改变。
鉴别诊断:
- 急性淋巴母细胞白血病 : 高母细胞计数(常>90%)与本病(M1)相似,细胞形态有时也重叠,但表达 B 或 T 特异抗原,不表达 MPO。
- 急性未分化白血病 :形态学和免疫学上均无髓系分化特征。胞质无颗粒,不含 Auer 小体;只表达早期未成熟抗原如 CD34 和 HLA-DR,不表达 MPO(或特异淋系抗原)。
- 急性髓系白血病伴微小分化 :形态学上无髓系分化特征(胞质无颗粒,不含 Auer 小体),细胞化学染色 MPO ❤️% ,但免疫表型上符合髓系。